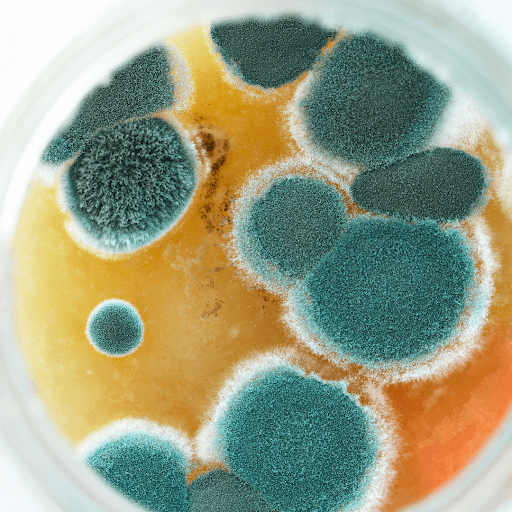

The air we breathe in our homes is often overlooked. Yet, it can have a significant impact on our health and well-being.
Indoor air quality can be 2 to 5 times worse than outdoor air. Common pollutants like mold spores, dust mites, and volatile organic compounds (VOCs) lurk in our living spaces.
In this blog post, we will help you understand the hidden dangers in your home and provide actionable advice on improving your indoor air quality, ensuring a healthier environment for you and your family.
Understanding Indoor Air Quality
Indoor air quality is the air quality within and around buildings and structures. It's crucial to our health as we spend most of our time indoors.
Poor indoor air quality can lead to immediate health issues like headaches, fatigue, and irritation of the eyes, nose, and throat. Long-term effects can be even more severe, leading to respiratory diseases, heart disease, and cancer.
Here are some key factors that can affect indoor air quality:
Ventilation and filtration
Humidity levels
Presence of indoor pollutants
Building materials and furnishings
Household cleaning and maintenance habits
Outdoor air quality
Common Indoor Air Pollutants
Numerous pollutants can degrade indoor air quality. Some of the most common include mold spores, dust mites, pet dander, and volatile organic compounds (VOCs).
Mold spores are microscopic fungi that thrive in damp environments. They can cause allergic reactions and respiratory problems. Dust mites, another common allergen, are tiny bugs that live in household dust.
Pet dander, or tiny flecks of skin shed by animals with fur or feathers, can also trigger allergies. VOCs, on the other hand, are gases emitted by certain solids or liquids. They include a variety of chemicals, some of which may have short- and long-term adverse health effects.
Health Impacts of Poor Indoor Air Quality
Poor indoor air quality exposure can lead to various health issues. Immediate effects often resemble those of a cold or other respiratory condition. Symptoms include sneezing, coughing, fatigue, dizziness, and headaches.
Long-term exposure can lead to more serious health problems like respiratory diseases, heart disease, and even cancer. The severity of these health effects depends largely on the type and concentration of pollutants and the duration of exposure.
Recognizing Symptoms and Long-Term Effects

Recognizing the symptoms of poor indoor air quality can be tricky. This is because they often resemble those of common illnesses. However, if symptoms persist or improve when you leave your home, poor indoor air quality may be the cause.
Long-term effects of exposure to poor indoor air quality can take years to show up. They can also significantly affect your quality of life. Regular health check-ups and monitoring your indoor air quality can help detect and mitigate these effects early.
Sources of Indoor Air Pollution
Indoor air pollution can come from a variety of sources. These include household products, building materials, and outdoor pollutants that make their way inside. Activities such as cooking, cleaning, smoking, and even breathing can release pollutants into the air.
Mold, dust mites, pet dander, and VOCs are common indoor pollutants that can accumulate to harmful levels if not properly managed. Regular cleaning and maintenance can reduce these pollutants and improve indoor air quality.
The Role of Mold and Moisture
Mold and moisture play a significant role in indoor air pollution. Mold spores can be released into the air and inhaled, causing health problems. High humidity levels, leaks, and poor ventilation can all contribute to mold growth.
Mold remediation is essential for removing existing mold and preventing future growth. This process should be conducted by professionals to ensure complete eradication and prevent health risks. Regular inspections can also help detect mold early and prevent its spread.
Flood Damage and Water Restoration's Impact
Flood damage can significantly deteriorate indoor air quality promoting mold growth and contaminating the air with bacteria. Therefore, addressing flood damage quickly is crucial for maintaining good indoor air quality.
Water damage restoration is a key part of this process that helps prevent the spread of moisture-related air pollutants. Searching for "water damage restoration" can help homeowners find local experts to address these issues. Regular maintenance can also prevent the need for extensive restoration work.
Strategies for Improving Indoor Air Quality
Improving indoor air quality involves a combination of strategies like reducing sources of pollution, increasing ventilation, and using air cleaners. Regular maintenance of home systems, such as HVAC and plumbing, can also prevent unexpected air quality problems.
Using dehumidifiers and proper ventilation can help maintain healthy indoor air quality. Regular cleaning and vacuuming with HEPA-filtered devices can reduce indoor pollutants. It's also important to address water leaks promptly to prevent mold growth and protect air quality.
Mold Remediation and Removal

Mold remediation and removal are crucial steps in improving indoor air quality. Professional mold remediation services can provide comprehensive solutions to restore air quality after mold damage. They can also provide advice on preventing future mold growth.
Searching for "mold remediation near me" can help homeowners find local experts to address mold issues. Remember, DIY mold removal may not be sufficient for severe infestations. Professional services ensure the complete eradication and prevent health risks.
Ventilation and Filtration Solutions
Ventilation and filtration are key strategies for maintaining healthy indoor air. Properly sealing and insulating the home can reduce drafts and prevent outdoor pollutants from entering. Using exhaust fans in bathrooms and kitchens can reduce moisture and pollutants.
Air purifiers with HEPA filters can remove airborne contaminants and improve air quality. Ensuring that HVAC systems are clean and filters are regularly replaced can improve indoor air circulation and quality. Energy recovery ventilators (ERVs) can also help maintain fresh air in tightly sealed homes.
Choosing Professional Services

When it comes to improving indoor air quality, professional services can be invaluable. They can provide comprehensive solutions, from mold remediation to flood damage restoration. Professionals can also conduct thorough inspections to identify hidden air quality issues.
It's important to choose a reputable company with professional certifications and standards. They should have experience in dealing with a variety of indoor air pollutants. Remember, the cost of proactive indoor air quality management can lead to long-term savings.
Finding the Right Mold Remediation and Restoration Company
Finding the right mold remediation and restoration company is crucial. A good company will provide comprehensive services, from mold removal to restoration of damaged areas. They should also offer advice on preventing future mold growth.
When searching for a company, consider its reputation, experience, and customer reviews. You can start by searching for "mold remediation near me" or "mold restoration company". Remember, improving indoor air quality is an investment in your health and the value of your property.
Conclusion: Taking Action to Protect Your Indoor Air
Improving indoor air quality is not just about comfort, it's about health. From addressing mold growth to managing humidity levels, every action contributes to a healthier living environment. Awareness and proactive management are key to maintaining good indoor air quality.
Whether you choose to do it yourself or hire professionals, taking steps to improve your indoor air quality is a worthwhile investment. It can lead to better health, increased productivity, and even enhance the value of your property. So, don't wait. Start taking action today to protect your indoor air.
For expert mold remediation and comprehensive air quality solutions, contact The Healthy Environments today!
